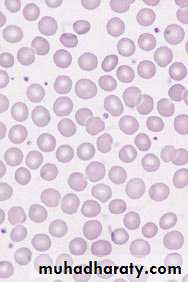
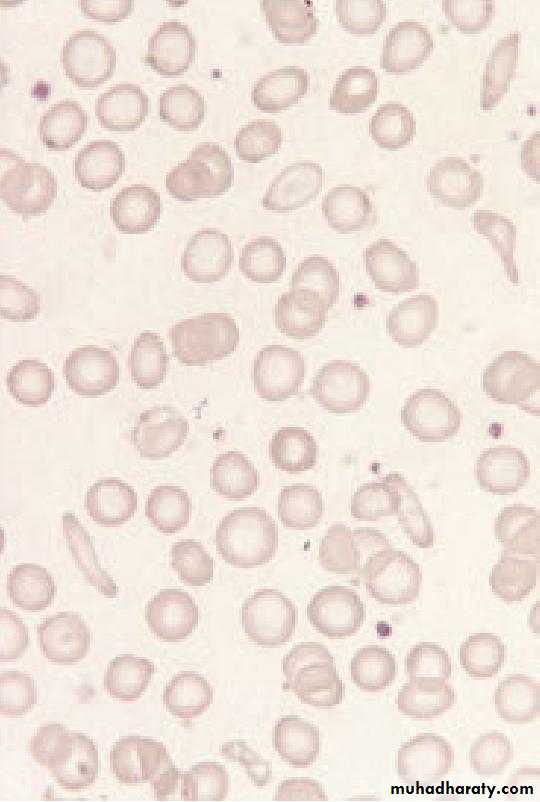
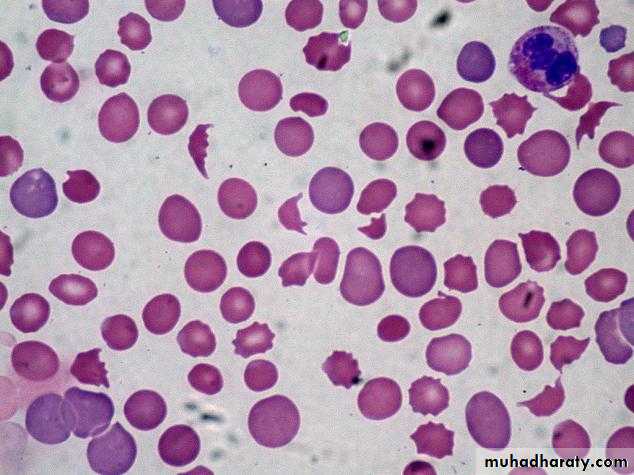

Childhood Anemia5th year medical students
Dr. Salma Al-HadadApril 5th 2016
Childhood Anemia
Objectives:To define anemia
To list the general causes of anemia
To list the signs and symptoms of anemia
To outline the steps for diagnosis of anemia
To describe the clinical presentation and management of iron deficiency anemia in children
Define Hemolytic anemia & list the sites of hemolysis
Childhood Anemia
Definition of anemiaAnemia can be defined as a reduction in the hemoglobin (Hb) concentration, hematocrit, or number of red blood cells (RBC) per cubic milliliter below normal for age and gender specific values
Anemia is a sign, not a disease
Childhood Anemia
Normal Hematopoiesis:Hemoglobin is high at birth (14-20g/dl) and falls during the initial 6 to 8 weeks of life to a physiologic nadir (9.5g/dl) before it gradually increases to childhood levels (10.5-14.5g/dl).
Childhood Anemia
Scenarios of presentationA child who is feeling well but is found to have anemia
on a routine screening test,
A child who is “tired” and does not eat well,
A child who is being evaluated for other chronic
problems and is found to have anemia,
A child who is obviously pale, lethargic & requires
immediate assessment.
Childhood Anemia
General causes of anemia:• 1. Poor production of red blood cells;
• Nutritional deficiencies—iron, vitamin B12, folic acid.
• Reduction in erythroid precursors— aplasia, BM infiltration, leukemia.
• Ineffective erythropoiesis: failure of apparently active erythropoiesis to produce adequate number of circulating red cells—Thalassaemia
2. Destruction of red blood cells i.e. hemolysis
3. Loss of red blood cells, i.e. bleeding
Childhood Anemia
A practical approach to the evaluation of the anemic child
• Step 1: confirm anemia by using age and gender specific tables
• Step 2: evaluate the red cell indices, of these; the mean corpuscular volume (MCV) is the most useful. It enables the classification of anemia by red blood cell size as microcytic, normocytic, or macrocytic.
• Step 3: assess WBC & platelet counts. Is the anemia isolated or are other cell lines affected?
• Step 4: Microscopic examination of the blood film can assess the size, color, and shape of the red cells, also the presence of abnormal cells.
Childhood Anemia
Symptoms:Many children with anemia have no symptoms. That's why it's important for children to have routine blood tests.
Due to reduced supply of oxygen—Fatigue, dyspnea on exertion, faintness, palpitations, dizziness, headache.
In older subjects symptoms of cardiac failure, angina pectoris, or confusion.
• Other important parts of history:
• Patient History; Diet history (type/quantity of milk, Ingestion of non-food items), medications, Activity level, Acute or recent infection, chronic diseases.
• Family History; Ethnicity, Anemia, Jaundice, Splenomegaly, Gallstones, Bleeding disorders, transfusions
Adaptation to anemia
Reduction in delivery of oxygen to the tissues triggers a variety of compensatory mechanisms, including• Modulation of oxygen affinity—largely mediated by an increase in red blood cell 2,3-biphosphoglycerate;
• Increased production of erythropoietin—the main growth factor for red blood cell production;
• Redistribution of flow to benefit the myocardium, brain, and muscle;
• Increase in cardiac output
Childhood Anemia
Clinical manifestations
The clinical picture depends on whether anemia is of rapid or insidious onset.
• Acute blood loss presents with features of intravascular volume depletion
• Anemia of gradual onset may (if mild) be asymptomatic or simply manifest as slight fatigue and pallor, or
• (if more severe) present with features including exertional dyspnea, tachycardia, palpitations, angina, faintness, and signs of ‘cardiac failure’.
Childhood Anemia
• Other signs related to the cause of anemia:
• Jaundice points to a hemolytic process.• Splenomegaly may be seen in inherited hemolytic anemia, malignancy, acute infection, or hypersplenism secondary to portal hypertension.
• Petechial rash indicates multiple cell lineages are involved.
Childhood Anemia
Age-related differences in incidence• Newborn: Acute anemia most commonly occurs among newborns.
• Significant blood loss can occur from birth trauma or blood exchange from the baby's mother (feto-maternal transfusion) or the placenta.
• Isoimmune anemia can result from maternal antibodies crossing the placenta.
• Abnormalities of fetal hemoglobin may cause anemia, Deletion of α globin gene, unlike β globin gene mutation, causes anemia in neonates.
Childhood Anemia
• Age-related differences in incidence
• Infancy: Nutritional anemia is common in infancy because of the associated rapid growth (necessitating an increase in red blood cell mass) and dietary adjustments.
• Early childhood: With exposure to new infections in early childhood, the anemia of acute infection is common.
• Adolescence: is characterized by rapid growth and vulnerability to nutritional anemia. In addition, blood loss with heavy menstruation can be observed in adolescent girls.
Childhood Anemia
Case 1A 15-month-old male infant presented with poor appetite, lethargy and progressive increasing paleness of body for last 2 months.
The child was born preterm at 32 weeks of gestation with a birth weight of 1.8kg. He is predominantly on cow's milk and consumes 500ml/day. No other significant medical history. There is no history of passage of worms in stool. There is no past history of blood transfusion or family history of any disorder requiring repeated transfusions.
O/E; There is presence of conjunctival and palmar pallor but no signs suggestive of cutaneous or mucosal bleeding. Jugular venous pressure is not raised, and there is no lymphadenopathy or organomegaly.
Hb 8g/dl, WBC 5,800/cmm, MCV 70 fL
Nutritional Deficiency Anemia in Children
• The term ‘nutritional anemia’ due to a deficiency in one or several nutrients. The main nutrients involved in the synthesis of hemoglobin are iron, folic acid, and vitamin B12.• In public health terms, iron deficiency is by far the first cause of nutritional anemia worldwide.
• Folic acid deficiency is less widespread and is often observed with iron deficiency.
• Vitamin B12 deficiency is far rarer.
Childhood Anemia
Iron deficiency anemia (IDA)
Causes of IDA:
1. Poor intake:
• Inadequate dietary iron (unusual before 6 months but becomes common at 9-24 month of age) by consumption of large amounts of cow’s milk and of foods not supplemented with iron.
Malnutrition
2. Increased demands:
low birth weight (low body iron stores then rapid growth)
Causes of IDA:
3. Blood loss:• A lesion of the GIT, such as a P.U., Meckel’s diverticulum, a polyp, or by inflammatory BD.
• Hookworm infestation is an important cause of iron deficiency, e.g. Ancylosotma duodenale
• Any site outside GIT, e.g. nose, trauma, lung, kidney
4. Malabsorption: e.g. celiac disease, partial gastrectomy
Iron deficiency anemia (IDA)
Iron deficiency anemia (IDA)Clinical features of IDA
• General symptoms and signs of anemia
• Symptoms and signs specific to iron deficiency: Patients with long-standing deficiency may develop changes like:
• Nail flattening and koilonychia (concave nail),
• Sore tongue and papillary atrophy,
• Angular stomatitis (painful cracks appear at the angle of the mouth).
• Psychomotor delay and behavioral problems in young children.
• Symptoms and signs due to the underlying cause of iron deficiency
• Painful cracks appear at the angle of the mouth
Angular Stomatitis
Iron deficiency anemia
What is A Pale, Smooth, Burning Tongue?
An alteration in tongue tissue characteristic of iron deficiency.Koilonychia:
"spoon nails” Iron deficiency anemiaIron deficiency anemia (IDA)
Diagnosis of IDA:The blood counts:
• Low Hb
• Low MCV, MCH, and MCHC
• Blood film: microcytic hypochromic red cells
Confirmatory tests:
• Low serum iron
• Increased total iron binding capacity
• Serum ferritin is probably the most useful of these tests.
Iron deficiency anemia (IDA)
• MCV
• MCH
• MCHC N
• Fe
• TIBC
• TRANSFERIN SATURATION
• FERRITIN
Blood films
Normal red blood cellsHypochromic Microcytic
Iron deficiency anemia (IDA)
Treatment of IDA; Principles• Use oral iron
• Replace iron in total (8 wk. after blood values are normal)
• Establish and treat the cause (e.g. GI blood loss).
• Therapeutic dose should be calculated in terms of elemental iron
• A daily total of 6 mg/kg of elemental iron in 3 divided doses
• Response of IDA to iron is an important Dx. & Rx. Feature.
Iron deficiency anemia (IDA)
Response:
Reticulocyte count should rise in 5-10 days & Hb should increase by 1 g/dl/wk.
Failure to respond to oral iron therapy due to:
• Wrong diagnosis (i.e. other cause of anemia like B-Thalassemia minor)
• Inadequate dose
• Non-compliance (The child does not receive the prescribed medication)
• Malabsorption
• Continued bleeding (as intestinal or pulmonary loss, or with menstrual periods).
• When iron is given in a form that is poorly absorbed
• Severe infection
Iron deficiency anemia (IDA)
Parenteral therapy; iron dextranA parenteral iron preparation (iron dextran) is an effective form of iron
Indications
• Poor compliance
• Intolerance of oral iron
• Severe bowel disease
• Chronic hemorrhage
• Acute diarrhea disorder
The rise in Hb concentration is not faster than with oral iron therapy.
Iron deficiency anemia (IDA)
Prevention
Breast feeding until 5-6 mo, beyond 6 mo add Fe supplementation
Iron-fortified formula for first 12 mo
Iron-fortified cereal early with solid foods
Avoid cow’s milk until 9-12 mo
Case 2 B-Thalassemia minor
A 5-year-old male child presented with complaint of pallor since early childhood.no history of bleeding, weight loss, jaundice or blood transfusion in past.
O/E active and playful. he was pale but there was no icterus, cyanosis, clubbing, lymphadenopathy or hepatosplenomegaly, the rest of the systemic examination was normal.
Hb 9g/dl, MCV 60fL, hypochromic microcytic RBC.
RBC 6.5 million/cmm, Iron 35mg/dl, TIBC: 350 mg/dl, Ferritin 25 ng/ml
β-Thalassemia Minor or Trait (Heterozygous β0 or β+)
Clinical FeaturesAsymptomatic (physical examination is normal)a. Discovered on routine blood test: slightly reduced hemoglobin, basophilic stippling, low MCV, normal RDW.
Discovered in family investigation or family history of heterozygous or homozygous β-thalassemia.
Confirmed with hemoglobin electrophoresis, demonstrating slightly decreased hemoglobin A (90–95% typically), increased hemoglobin A2 (>4%); hemoglobin F mildly elevated in 50% of cases.
Hemolytic Anemia
Anemia, Reticulocytosis, Indirect hyperbilirubinemiaDescribes a group of anemia that are characterized by abnormal destruction of red cells. The hallmark of these disorders is reduced life span of the red cells rather than underproduction by the bone marrow.
The RBC normally survives about 120 days, but in hemolysis the cell survival times are considerably shortened.
Childhood Anemia
Pallor and jaundice
• Sites of hemolysis
• I. Intravascular hemolysis: When RBC are rapidly destroyed within the circulation, hemoglobin is liberated, e.g.• Glucose-6-phosphate dehydrogenase (G6PD) deficiency,
• Hemolytic Uremic Syndrome
• Disseminated intravascular coagulation(DIC)
• Following transfusion of ABO incompatible blood,
• Hemolytic anemia due to prosthetic cardiac valves and
• Paroxysmal nocturnal hemoglobinuria (PNH)
Childhood Anemia
II. Extravascular hemolysis:
The red cells are removed from the circulation by macrophages in the RES, particularly the liver and spleen. e.g. Autoimmune hemolytic anemia and Hereditary spherocytosis.
III. Intramedullary hemolysis:
Hemolysis may also be intramedullary when fragile RBC precursors are destroyed in the bone marrow prior to release into the circulation. e.g. Thalassemia major.
Childhood Anemia
• Laboratory findings:
• I. Increased RBC breakdown (intra or extra• vascular hemolysis)
• Increased unconjugated serum bilirubin
• Increased urine urobilinogen
• Increased faecal stercobilinogen
• Absent serum haptoglobin, because it becomes saturated with Hb.
II. Increased RBC production
• Reticulocytosis
• Bone marrow erythroid hyperplasia
Childhood Anemia
Laboratory findings
III. Damaged RBC• Morphology; microspherocytes, elliptocytes, fragments
• Osmotic fragility, autohemolysis
• Shortened RBC survival
Childhood Anemia
40
41
42
43
Classification of Hemolytic Anemia
• I. Inherited disorders• RBC membrane defect; Hereditary Spherocytosis and Hereditary Elliptocytosis
• Enzyme defect; Glucose –6 –phosphate dehydrogenase and Pyruvate kinase deficiency
• Hemoglobin defects; Thalassemia syndromes and Sickling disorders
Classification of Hemolytic Anemia
• II. Acquired disordersImmune mediated;
• I. Auto immune (autoimmune hemolytic anemia),
• II. Alloimmune (hemolytic disease of newborn,
• hemolytic transfusion reaction)
Non-immune and trauma; valve prosthesis, microangiopathy, infection, drugs or chemicals, hypersplenism, secondary (liver and renal disease)